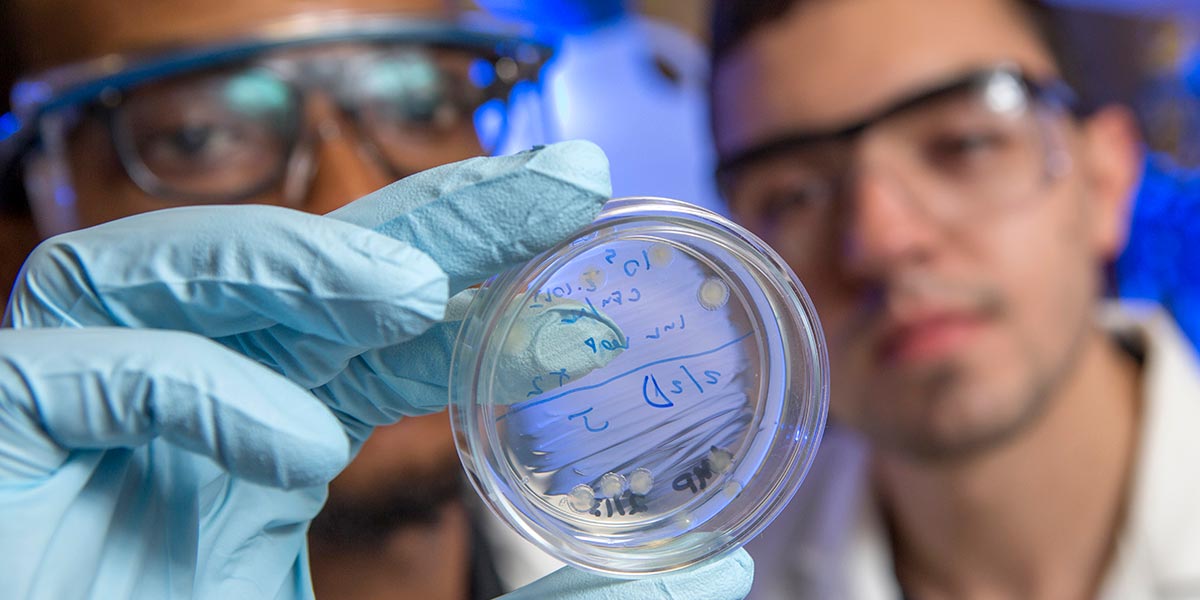

Building engineering skills and research relevant for today’s career focus
The FAMU-FSU College of Engineering is the joint engineering school for Florida A&M and Florida State universities, the only shared college of engineering in the nation. We are located less than three miles from each campus. Our students enroll (and graduate) as Seminoles or Rattlers and start their college experience on the home campus. Once prerequisites are complete, they learn together at our engineering building.
We are surrounded by eight partner research centers and a national laboratory. This unique collaboration between a top Historically-Black University and a Research-1 institution makes us a great place to learn cutting-edge engineering skills in a diverse environment offering real-world experience that employers value.
Your launch pad to an engineering career starts with our bachelor’s
and graduate degree programs.
Degree Programs
We offer graduate and undergraduate degrees through our five departments, including:
| BS | MS (Non-Thesis) | MS | Ph.D. | |
|---|---|---|---|---|
| Aerospace Engineering | X | X | X | X |
| Biomedical Engineering | X | X | X | X |
| Chemical Engineering | X | X | X | X |
| Civil Engineering | X | M.Eng | X | X |
| Computer Engineering | X | |||
| Electrical Engineering | X | X | X | X |
| Engineering Management | X | |||
| Environmental Engineering | X | |||
| Industrial Engineering | X | X | X | |
| Materials Science & Engineering | X | X | ||
| Mechanical Engineering | X | X | X | X |
| Sustainable Energy | X | |||
| Systems Engineering | X |
Engineering Departments and Degrees
Chemical & Biomedical Engineering
Chemical engineers are involved in the manufacturing of products as varied as petrochemicals, plastics, textiles, pharmaceuticals, medical devices, biochemicals, metals and semiconductors. Biomedical engineers apply engineering to human health, often working on medical research. We offer BS, MS and Ph.D. degrees in both chemical and biomedical engineering.
Civil & Environmental Engineering
Civil engineers play a vital role in creating man-made infrastructure and protecting the natural environment. They develop, improve, plan, design, construct and operate facilities essential to modern life ranging from buildings to transit systems. We offer a bachelor’s degree in civil engineering with an option for environmental engineering, as well as several graduate degrees in civil engineering.
Electrical & Computer Engineering
Electrical engineers develop circuits, systems and networks used for electrical power generation/distribution, machine and process control, wireless and satellite communications and more. Computer engineers apply the software skills of a computer scientist with the hardware skills of an electrical engineer. We offer a bachelor’s degree in computer engineering, plus a bachelor’s and several graduate degrees in electrical engineering.
Industrial & Manufacturing Engineering
Industrial engineers bring innovation and efficiency to service and manufacturing industries including healthcare, transportation, food and pharmaceuticals. Skills in quality control, machine learning, manufacturing optimization and manufacturing of advanced materials are key. We offer a bachelor’s and graduate degrees in industrial engineering. In addition, we have specialized MS programs in engineering management and systems engineering.
Mechanical Engineering
Mechanical engineers analyze, design and control thermal-fluid systems, structural and materials systems or dynamic and mechatronic systems. These engineers are hired in every industry from automotive to biomedical. We offer BS, MS and Ph.D. in mechanical engineering, as well as a MS in sustainable energy.
Locations
FAMU-FSU Engineering offers classes at the main campus in Tallahassee’s Innovation Park (less than three miles from FSU and FAMU campuses) and through FSU-Panama City (FL).
Admissions
Become a Seminole engineer by applying today. Take a look at our admissions process and requirements for Undergraduates and Graduate Students.